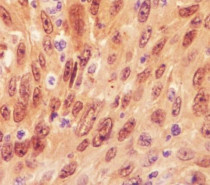

ARG57603
anti-IRF3 antibody
anti-IRF3 antibody for Flow cytometry,ICC/IF,IHC-Formalin-fixed paraffin-embedded sections,Western blot and Human,Mouse,Rat
Overview
| Product Description | Rabbit Polyclonal antibody recognizes IRF3 |
|---|---|
| Tested Reactivity | Hu, Ms, Rat |
| Tested Application | FACS, ICC/IF, IHC-P, WB |
| Host | Rabbit |
| Clonality | Polyclonal |
| Isotype | IgG |
| Target Name | IRF3 |
| Antigen Species | Human |
| Immunogen | Synthetic peptide derived from Human IRF3. |
| Conjugation | Un-conjugated |
| Alternate Names | IRF-3; Interferon regulatory factor 3 |
Application Instructions
| Application Suggestion |
|
||||||||||
|---|---|---|---|---|---|---|---|---|---|---|---|
| Application Note | * The dilutions indicate recommended starting dilutions and the optimal dilutions or concentrations should be determined by the scientist. |
Properties
| Form | Liquid |
|---|---|
| Purification | Affinity purified. |
| Buffer | PBS (pH 7.4), 150mM NaCl, 0.02% Sodium azide and 50% Glycerol. |
| Preservative | 0.02% Sodium azide |
| Stabilizer | 50% Glycerol |
| Storage Instruction | For continuous use, store undiluted antibody at 2-8°C for up to a week. For long-term storage, aliquot and store at -20°C. Storage in frost free freezers is not recommended. Avoid repeated freeze/thaw cycles. Suggest spin the vial prior to opening. The antibody solution should be gently mixed before use. |
| Note | For laboratory research only, not for drug, diagnostic or other use. |
Bioinformation
| Database Links | |
|---|---|
| Gene Symbol | IRF3 |
| Gene Full Name | interferon regulatory factor 3 |
| Background | This gene encodes a member of the interferon regulatory transcription factor (IRF) family. The encoded protein is found in an inactive cytoplasmic form that upon serine/threonine phosphorylation forms a complex with CREBBP. This complex translocates to the nucleus and activates the transcription of interferons alpha and beta, as well as other interferon-induced genes. Alternatively spliced transcript variants encoding multiple isoforms have been observed for this gene. [provided by RefSeq, Nov 2011] |
| Function | Key transcriptional regulator of type I interferon (IFN)-dependent immune responses which plays a critical role in the innate immune response against DNA and RNA viruses. Regulates the transcription of type I IFN genes (IFN-alpha and IFN-beta) and IFN-stimulated genes (ISG) by binding to an interferon-stimulated response element (ISRE) in their promoters. Acts as a more potent activator of the IFN-beta (IFNB) gene than the IFN-alpha (IFNA) gene and plays a critical role in both the early and late phases of the IFNA/B gene induction. Found in an inactive form in the cytoplasm of uninfected cells and following viral infection, double-stranded RNA (dsRNA), or toll-like receptor (TLR) signaling, is phosphorylated by IKBKE and TBK1 kinases. This induces a conformational change, leading to its dimerization and nuclear localization and association with CREB binding protein (CREBBP) to form dsRNA-activated factor 1 (DRAF1), a complex which activates the transcription of the type I IFN and ISG genes. Can activate distinct gene expression programs in macrophages and can induce significant apoptosis in primary macrophages. [UniProt] |
| Cellular Localization | Nucleus |
| Highlight | Related products: IRF3 antibodies; Anti-Rabbit IgG secondary antibodies; Related news: Exploring Antiviral Immune Response circNDUFB2, a circular RNA (circRNA), activates anti-tumor immunity |
| Calculated MW | 47 kDa |
| PTM | Constitutively phosphorylated on many Ser/Thr residues. C-terminal serine/threonine cluster is phosphorylated in response of induction by IKBKE and TBK1. Phosphorylated at Ser-396 by IKBKE upon ssRNA viral infection. Ser-385 and Ser-386 may be specifically phosphorylated in response to induction. Phosphorylation at Ser-386 by TBK1 results in oligomerization. An alternate model propose that the five serine/threonine residues between 396 and 405 are phosphorylated in response to a viral infection. (Microbial infection) Phosphorylation and subsequent activation of IRF3 is inhibited by vaccinia virus protein E3. Ubiquitinated; ubiquitination involves RBCK1 leading to proteasomal degradation. Polyubiquitinated; ubiquitination involves TRIM21 leading to proteasomal degradation. ISGylated by HERC5 resulting in sustained IRF3 activation and in the inhibition of IRF3 ubiquitination by disrupting PIN1 binding. The phosphorylation state of IRF3 does not alter ISGylation. [UniProt] |
Images (3) Click the Picture to Zoom In
-
ARG57603 anti-IRF3 antibody ICC/IF image
Immunofluorescence: Jurkat cells stained with ARG57603 anti-IRF3 antibody.
-
ARG57603 anti-IRF3 antibody IHC-P image
Immunohistochemistry: Paraffin-embedded Human cervix carcinoma stained with ARG57603 anti-IRF3 antibody.
-
ARG57603 anti-IRF3 antibody WB image
Western blot: 3T3 cell lysate stained with ARG57603 anti-IRF3 antibody.